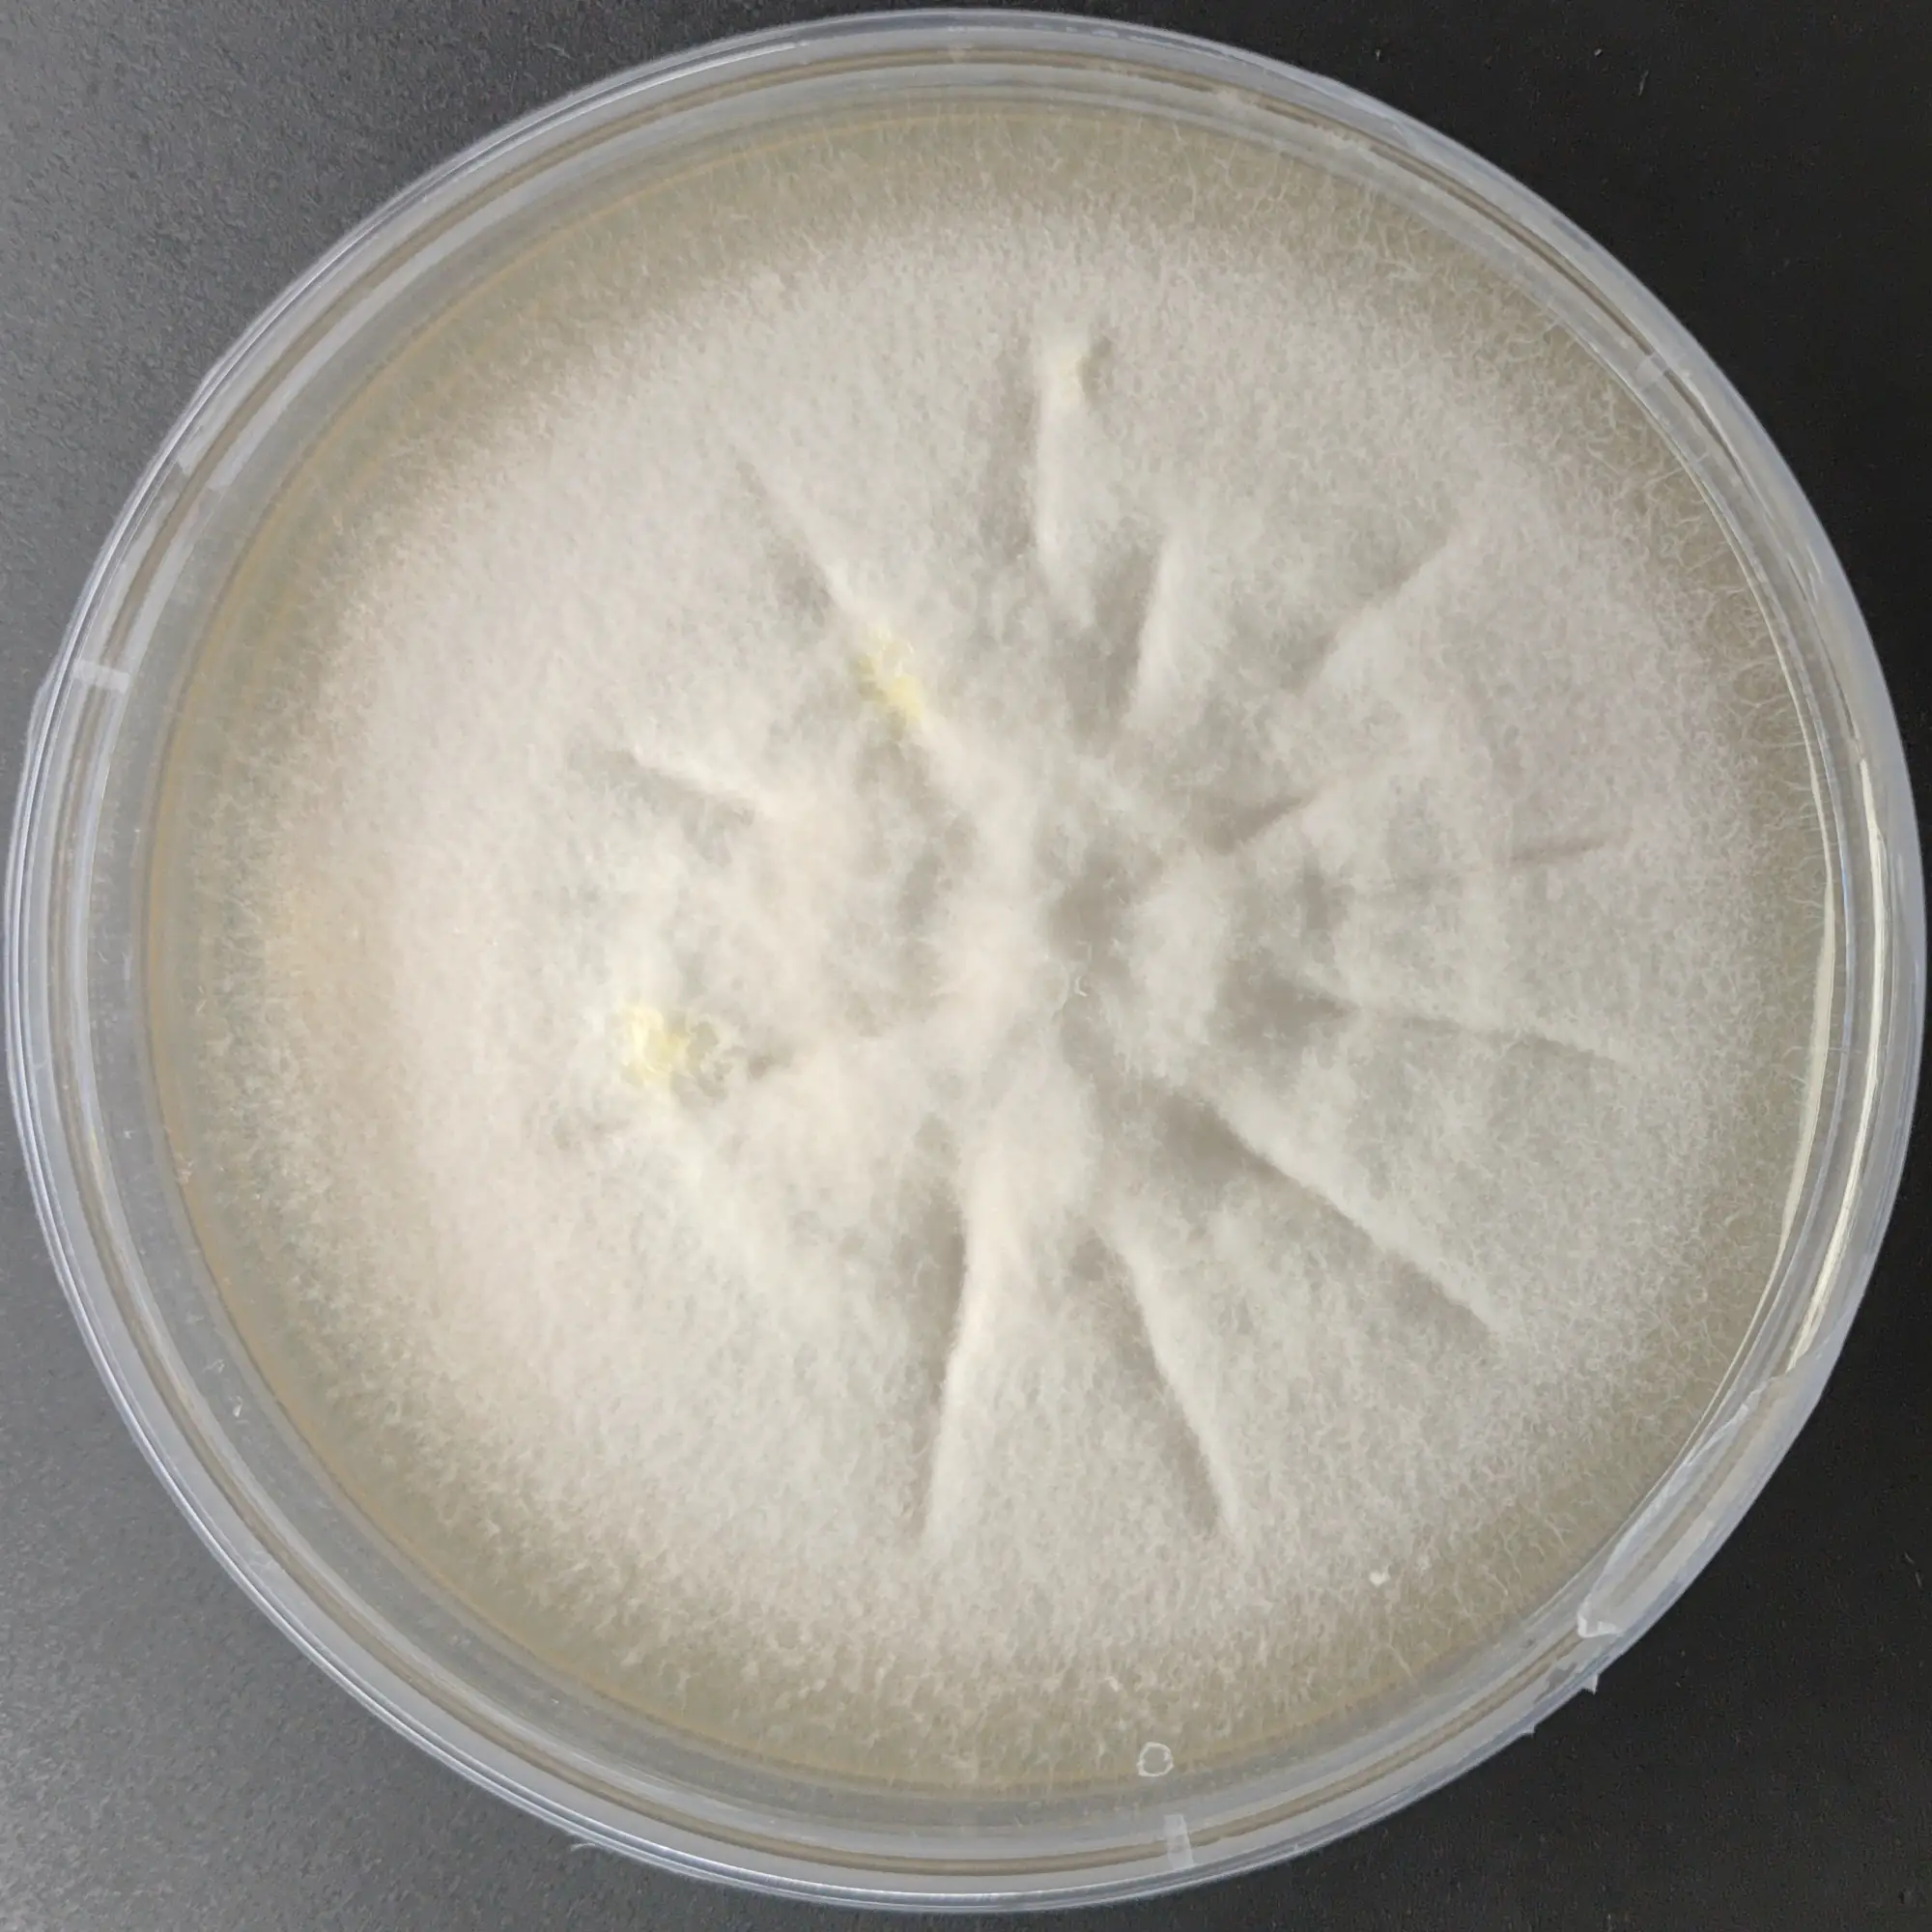
F115 Langermannia gigentea.webp

Agaricus augustus Culture Plate (Prince mushroom)
Agaricus bisporus Button Mushroom Culture Plate
Agaricus brunnescens Champignon mushroom Culture Plate
Agaricus subrufescens Almond mushroom Culture
Black Morel Culture Plate (Morchella importuna)
Black Poplar Mushroom Culture (Cyclocybe aegerita)
Ceriporus squamosus Dryad’s Saddle culture
MUHSROOM CULTURE BANK PURE CULTURE - INDUSTRIAL FUNGUS PURE CULTURE - SPECIALTY MUSHROOMS All Products
Enoki Mushroom Pure Culture (Flammulina velutipes)
Fomes fomentarius Hoof Fungus Culture Plate
MUHSROOM CULTURE BANK PURE CULTURE - INDUSTRIAL FUNGUS PURE CULTURE - SPECIALTY MUSHROOMS All Products
Giant Puffball Mushroom Culture (Langermannia gigantea)
Giant sawgill mushroom culture (Neolentins ponderosus)
Heat tolerant Lion’s mane Culture (Hericium erinaceus)
MUHSROOM CULTURE BANK PURE CULTURE - MEDICINAL MUSHROOMS PURE CULTURE - SPECIALTY MUSHROOMS All Products BESTSELLERS